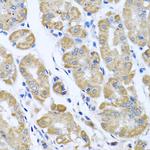
eIF2 gamma Antibody in Immunohistochemistry (Paraffin) (IHC (P))

Search
Invitrogen
eIF2 gamma Polyclonal Antibody
{{$productOrderCtrl.translations['antibody.pdp.commerceCard.promotion.promotions']}}
{{$productOrderCtrl.translations['antibody.pdp.commerceCard.promotion.viewpromo']}}
{{$productOrderCtrl.translations['antibody.pdp.commerceCard.promotion.promocode']}}: {{promo.promoCode}} {{promo.promoTitle}} {{promo.promoDescription}}. {{$productOrderCtrl.translations['antibody.pdp.commerceCard.promotion.learnmore']}}
图: 1 / 4
eIF2 gamma Antibody (PA5-76845) in IHC (P)

Please note: We are reviewing Western blot images included in the antibody testing data in our catalog, including those provided by third parties. Unless expressly labeled or annotated as “raw-unedited”, Western blot images included in the antibody testing data in our catalog may have been edited, optimized or otherwise adjusted for presentation.
产品信息
PA5-76845
种属反应
宿主/亚型
分类
类型
抗原
偶联物
形式
浓度
规格
纯化类型
保存液
内含物
保存条件
运输条件
RRID
产品详细信息
The antibody was affinity-purified from rabbit antiserum by affinity-chromatography using epitope-specific immunogen and the purity is > 95% (by SDS-PAGE).
靶标信息
The initiation of protein synthesis in eukaryotic cells is regulated by interactions between protein initiation factors and RNA molecules. The eukaryotic initiation complex is composed of three subunits, designated eIF2 alpha, eIF2 beta and eIF2 gamma (eukaryotic translation initiation factor 2 alpha, beta and gamma, respectively), all of which work in concert to form a ternary complex with GTP and tRNA in the early stages of protein synthesis. eIF2S3 (eukaryotic translation initiation factor 2, subunit 3), also known as eIF2G, is a 472 amino acid protein that belongs to the gamma subfamily of GTP-binding elongation factor proteins. Existing as a heterotrimer composed of an alpha, beta and gamma chain, eIF2S3 functions to bind ribosomal subunits and catalyze the subsequent formation of preinitiation complexes necessary for protein synthesis.
仅用于科研。不用于诊断过程。未经明确授权不得转售。
篇参考文献 (0)
生物信息学
蛋白别名: eIF-2-gamma; eIF2-gamma; eIF2-gamma X; Eukaryotic translation initiation factor 2 subunit 3; Eukaryotic translation initiation factor 2 subunit 3, X-linked; Eukaryotic translation initiation factor 2 subunit gamma; Eukaryotic translation initiation factor 2 subunit gamma X; Eukaryotic translation initiation factor 2 subunit gamma, X-linked; PP42
基因别名: EIF2G; EIF2S3; Eif2s3x; PP42
UniProt ID: (Rat) P81795
Entrez Gene ID: (Rat) 299027




